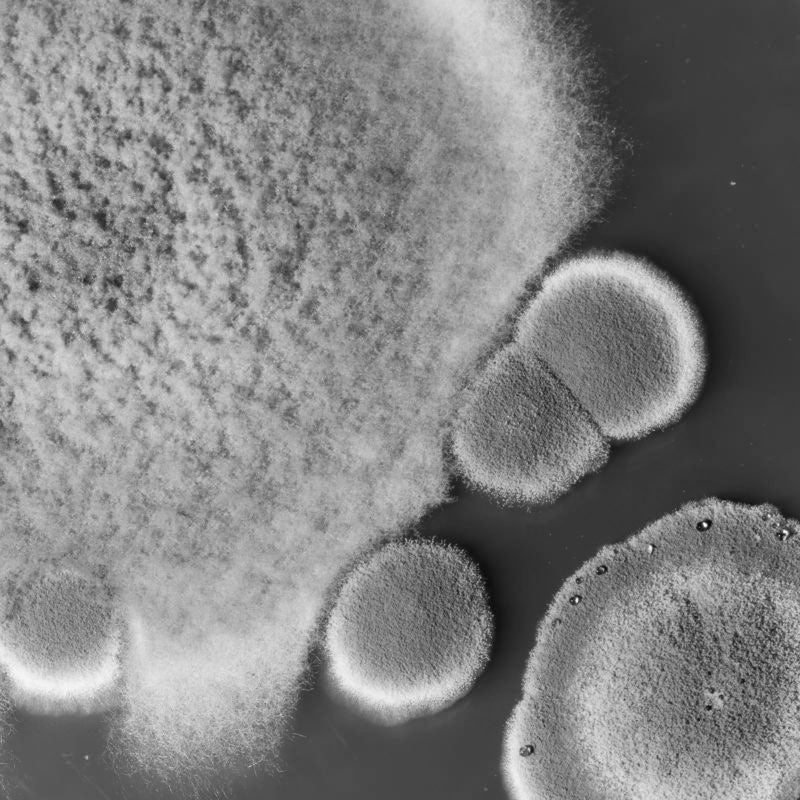

ELECTROLYTES, MINERALS, VITAMINS, FRUIT - ALL IN DRY POWDER FORM
34 Ingredients, 3 Flavors with a purpose, rigorously tested, and completely clean.

ELECTROLYTES, MINERALS, VITAMINS, FRUIT - ALL IN DRY POWDER FORM
34 Ingredients, 3 Flavors with a purpose, rigorously tested, and completely clean.
NOTE:YOU CAN SEE SMALL FLAKES OF FRUIT IN EACH BLEND


Ingredient List
Potassium is a fundamental ingredient in each blend of DryWater® for several important reasons. Firstly, potassium is essential for maintaining proper fluid balance and hydration levels in the body. It supports healthy kidney function, facilitating efficient water balance and preventing dehydration. Secondly, potassium plays a key role in reducing fatigue and enhancing cognitive function, allowing you to perform at your best. Additionally, it supports muscle strength and function, promoting optimal physical performance. By incorporating potassium into our formulations, we ensure that our products effectively replenish electrolytes and support proper hydration, contributing to your overall well-being. A powerful 1,000mg dosage of potassium in each 11g stick will help you stay hydrated and perform at your peak.
Glycine, an essential amino acid that plays a crucial role in various bodily functions. Naturally present in the body and found in various foods, Glycine supports healthy brain function by acting as a neurotransmitter precursor, contributing to cognitive performance and mental well-being. It also promotes restful sleep by calming the nervous system and reducing sleep disturbances. Additionally, Glycine aids in muscle recovery and repair, facilitating post-workout muscle regeneration. With its wide-ranging benefits, Glycine is an indispensable component of our DryWater® hydration powder, helping optimize brain function, improve sleep quality, and enhance muscular recovery.
Our super fine Pink Sea Salt has a high concentration of minerals and electrolytes, which are essential to maintaining optimal hydration levels, help regulate fluid balance, improve absorption of H20 , reduce muscle cramps, and enhance athletic performance.
Magnesium citrate promotes muscle relaxation and electrolyte balance, reducing muscle cramps, enhancing hydration, and supporting heart health.
Calcium lactate supports muscle and nerve function during hydration while contributing to healthy bone density and overall wellness.
Our zinc oxide is sourced directly from Japan, renowned for its high purity and unique, tasteless profile. Unlike typical zinc supplements, this specially formulated zinc integrates seamlessly into our blend without altering the taste, while still providing powerful immune support and aiding in cell function. Crafted with an emphasis on quality and bioavailability, it’s an ideal, clean addition to help support your health.
Vitamin C (Ascorbic Acid) not only boosts immune function but also aids in collagen production, benefiting skin health, immune support, and overall well-being during hydration.
Vitamin B3 supports energy metabolism, skin health, and cognitive function, contributing to overall health during hydration.
Vitamin B5 (Calcium Pantothenate) plays a role in energy production and overall health, making it valuable during hydration.
Vitamin B6 aids in neurotransmitter function and helps maintain hydration, supporting physical and mental well-being.
Vitamin B12 (Methylcobalamin 1%) promotes nerve function, red blood cell production, and overall well-being during hydration, contributing to overall vitality.
L-Malic acid assists in energy production during hydration, helping to prevent muscle fatigue and enhancing physical performance. It also supports dental health.
We include organic banana powder in our formula for its natural potassium and magnesium, essential minerals that support hydration, muscle function, and electrolyte balance. In its powdered form, banana offers improved bioavailability, allowing your body to absorb these vital nutrients more efficiently. This easy-to-digest, antioxidant-rich powder also adds a gentle, natural sweetness to our blend, enhancing both taste and nutrition. Sourced organically and minimally processed, our banana powder is a clean, effective choice to fuel your active lifestyle.
Our blueberries fruit powder is one of the highest antioxidant levels of all common fruits and vegetables: blueberries are a super-fruit. It prevents aging in many cells in the body including the brain and the skin. It also accelerates muscle recovery.
Citric acid aids in the absorption of minerals, improving their effectiveness in promoting hydration. It also acts as an antioxidant, supporting overall health.
Our dry Organic coconut water powder is a natural source of electrolytes, helping to replenish fluids and maintain hydration. It also contains potassium and magnesium, supporting muscle and nerve function.
Cranberry juice powder supports hydration while contributing to urinary tract health, reducing the risk of infections, and offering antioxidants for overall well-being.
Our Dry Orange Juice Powder is a concentrated source of vitamin C and antioxidants, promoting immune support, skin health, and overall well-being.
Lime Juice powder
Known for its natural sweetness, Luo Han Guo is a small melon from Asia used for centuries in traditional Chinese wellness practices. It contains unique compounds called mogrosides, which are up to 250 times sweeter than sugar yet calorie-free. Along with providing a balanced and enjoyable taste without impacting blood sugar, monk fruit offers additional health benefits—its antioxidants help combat oxidative stress, while its anti-inflammatory properties support immune health. We use monk fruit as a clean, natural sweetener, making it an ideal choice for health-conscious, flavorful products.
Incorporating Mango Fruit Powder into our formula not only enhances its flavor but also provides essential vitamins, minerals, and antioxidants that support overall health and boost your immune system while keeping you hydrated.
Our dry Peach Fruit Powder is a nutrient-packed source of vitamins, minerals, and antioxidants. It can support skin health, aid digestion, and provide a boost of essential nutrients.
A nutrient powerhouse, beet juice powder is packed with natural nitrates, antioxidants, and essential nutrients. We use it to support healthy blood flow, boost energy levels, and enhance endurance, making it ideal for active lifestyles. Its high antioxidant content helps protect against cellular stress, while supporting heart health and natural detoxification. Along with these health benefits, we also use beet juice powder to provide a natural, vibrant color to our products. Clean and plant-based, beet juice powder is a healthful addition to our formula, promoting vitality with every sip.
Raspberry fruit powder
Bamboo Silica: Sourced from Bambusa vulgaris, bamboo silica is one of nature’s richest sources of silica (natural silicon dioxide) , containing up to 70-80%. We use it for its powerful support in collagen production, benefiting skin elasticity, hair strength, nail health, and joint function. Clean, natural, and minimally processed, bamboo silica enhances our commitment to wellness-focused products and high bioavailability.
Sodium citrate helps regulate fluid balance, making it essential for maintaining hydration. Additionally, it can help prevent kidney stones and improve exercise performance.
Stevia Leaf Extract: Cleanly extracted from the Stevia rebaudiana plant using a water-based process (no chemicals), our stevia plant leaf is a natural way to enhance sweetness. It perfectly complements our real fruit powders, providing a balanced flavor without impacting blood sugar levels or gut health. Each 11g stick contains just the right amount to amplify taste while maintaining our commitment to clean ingredients.
Strawberry dry-fruit powder; These overlooked delicious fruits are packed with vitamins, fiber, and particularly high levels of antioxidants. Just one serving provides more vitamin C than an orange. Another super-food.
Tartaric acid, found in various fruits, offers potential health benefits such as antioxidant protection, digestive support, and anti-inflammatory properties. It is commonly used in culinary and winemaking applications while promoting overall well-being when consumed in moderation as part of a balanced diet.

We believe that every ingredient in our products should have a purpose. That's why we prioritize using only safe and healthy ingredients, and avoid those that may cause harm in the long run. We understand that some cheaper and more convenient ingredients may come at a cost to our customers' health, so we are committed to choosing only high-quality ingredients that support overall wellness. This ensures that our customers can enjoy our products without worrying about any potential negative effects on their health.
- NO:SUGAR
- NO:GLUTEN
- NO:DAIRY
- NO:GLUCOSE
- NO:SUCROSE
- NO:LACTOSE
- NO:ARTIFICIAL COLORS
- NO:ARTIFICIAL SWEETENERS
- NO:ARTIFICIAL FLAVORS
ABSOLUTELY NO_
All of DryWater manufacturing facilities are NSF Certified® - we hold ourselves to the highest standards & extensive certification processes that includes strict analytical and microbiological testing on every batch of our Hydration Powder, including testing and verification on each one of our 35 ingredients. We also meet rigorous standards of testing and transparency with our manufacturers and suppliers, annual quality audits at every location in the manufacturing process and annual label audits for accuracy and efficacy.
We are interested in not only guaranteeing a healthy but also a pleasant experience. We carefully select organic fruits that have a great group of nutrients and dehydrate them so that we preserve all the goods that nature offers us while preserving their delicious flavor. On the other hand, for us it is important to respect the natural production cycle and that is why we choose to work with seasonal fruits in our formula, so you will find different flavors depending on the stage of the year in which we find.
How its made
01.
TYPE/ : 24 TRUSTED SUPPLIERS
NOTE/ : 92% OF OUR INGREDIENTS ARE SOURCED DIRECTLY IN THE UNITED STATES.
Suppliers and Sourcing
Our commitment to quality clean hydration powder starts with our sourcing practices, and each batch of ingredients is required to have a certificate of analysis. We carefully select and vet our suppliers to ensure they meet our strict standards for sustainability, ethical labor practices, and environmental responsibility. Through this process, we create a product that aligns with our values of health and wellness.
TYPE/ : 24 TRUSTED SUPPLIERS
NOTE/ : 92% OF OUR INGREDIENTS ARE SOURCED DIRECTLY IN THE UNITED STATES.


02.
TYPE/ : NSF
NOTE/ : EACH OF OUR 35 INGREDIENTS IS RIGOROUSLY TESTED
NSF Certified Facilites
All of our manufactures where DryWater is produced are NSF certified, which is is an extensive process that includes strict analytical and microbiological testing on every batch of DryWater Hydration Powder, including testing and verification on each one of our 35 ingredients. It also requires meeting rigorous standards of testing and transparency with our manufacturers and suppliers, annual quality audits at every location in the manufacturing process and annual label audits for accuracy and efficacy.
TYPE/ : NSF
NOTE/ : EACH OF OUR 35 INGREDIENTS IS RIGOROUSLY TESTED


03.
TYPE/ : GMP Certified
NOTE/ : EVERY SINGLE 11G STICK OF DRYWATER IS 100% TRACEABLE.
Manufacturing Process
We proudly manufacture in NSF Good Manufacturing Practice (GMP) registered facilities. Full batch testing and records mean every 11g stick of DryWater® is 100% traceable. Our manufacturers have a combined 95+ years of experience
TYPE/ : GMP Certified
NOTE/ : EVERY SINGLE 11G STICK OF DRYWATER IS 100% TRACEABLE.

When we prioritize our physical health, our mental and emotional well-being flourish. Nourishing our bodies with clean, wholesome, and natural ingredients is essential for vitality and longevity.
After all, it is our body that must show us the way.
TYPE/ : STICK INGREDIENTES _
C
B3
B5
B6
B12
POTASSIUM
CALCIUM
SODIUM
ZINC
CHLORIDE
GLYCINE
LEMONS
LIMES
ORANGES
BANANAS
COCONUTS
BLUEBERRIES
STRAWBERRIES
CRANBERRIES
PEACHES
MANGO